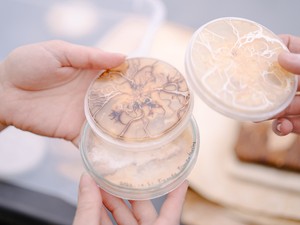
A szülői ház kőrisfáján felfedezett gomba lehet a fenntartható divatipar egyik titka - A Fraxinea alapítóival beszélgettünk

fenntartható divat

Divat
 Stella McCartney, a divattervező, aki a fenntarthatósági törekvésekben is élen jár
Stella McCartney, a divattervező, aki a fenntarthatósági törekvésekben is élen jár

Divat
 Dénes Barbara: A fenntarthatóság ott kezdődik, hogy a meglévő ruháinkat tesszük izgalmasabbá
Dénes Barbara: A fenntarthatóság ott kezdődik, hogy a meglévő ruháinkat tesszük izgalmasabbá

Divat
 Csókási Dorottya: A kreativitás öngyógyítás – ez a Chokassy márka egyik alapértéke
Csókási Dorottya: A kreativitás öngyógyítás – ez a Chokassy márka egyik alapértéke

Divat
 Divattervezők vagyunk, divattal akarunk foglalkozni, de fenntartható módon - beszélgetés a SECONDLAND és a BORBALA tervezőivel
Divattervezők vagyunk, divattal akarunk foglalkozni, de fenntartható módon - beszélgetés a SECONDLAND és a BORBALA tervezőivel

Divat
 Magyarországon a slow fashion trend még gyerekcipőben jár, de jó irányba haladunk - Beszélgetés Udvarnoki Eszterrel, a BASTION márka alapítójával
Magyarországon a slow fashion trend még gyerekcipőben jár, de jó irányba haladunk - Beszélgetés Udvarnoki Eszterrel, a BASTION márka alapítójával

 Ismerd meg a testalkatod, hogy formálhasd a jövőd: a testalkatelemzés lenne a fenntarthatóság kulcsa?
Ismerd meg a testalkatod, hogy formálhasd a jövőd: a testalkatelemzés lenne a fenntarthatóság kulcsa?

Palvin Barbara zavarba ejtő pólóban érkezett a párizsi divathétre, elmagyarázzuk a jelentését, mert mindenkinek ismernie kell

 Az a kérdés hajt, hogy igyekezzek választ adni a fenntarthatóság kihívásaira
Az a kérdés hajt, hogy igyekezzek választ adni a fenntarthatóság kihívásaira

 Így segíthetnek a gardróbrendszerező alkalmazások a fenntartható ruhatár kialakításában
Így segíthetnek a gardróbrendszerező alkalmazások a fenntartható ruhatár kialakításában

 Szerettem volna az emberekben tudatosítani a tényt, hogy a divatipar nagyban hozzájárul a klímaváltozáshoz - beszélgetés Fritzson-Bajdor Tündével, a Swappis Ruhaforgó alapítójával
Szerettem volna az emberekben tudatosítani a tényt, hogy a divatipar nagyban hozzájárul a klímaváltozáshoz - beszélgetés Fritzson-Bajdor Tündével, a Swappis Ruhaforgó alapítójával
A szülői ház kőrisfáján felfedezett gomba lehet a fenntartható divatipar egyik titka - A Fraxinea alapítóival beszélgettünk
A szülői ház kőrisfáján felfedezett gomba lehet a fenntartható divatipar egyik titka - A Fraxinea alapítóival beszélgettünk

Extra ajánló
Fenntarthatóbb őszi divat: ezek lesznek a szezon legmenőbb trendjei

Divat
 Nem kellenek súlyos összegek egy fenntartható ruhatár kialakításához
Nem kellenek súlyos összegek egy fenntartható ruhatár kialakításához

Életmód
 Second Hand September: 5 tipp, hogy hogyan vásárolj fenntarthatóan és stílusosan a használt ruhák világában
Second Hand September: 5 tipp, hogy hogyan vásárolj fenntarthatóan és stílusosan a használt ruhák világában

Divat
 A fenntartható divat nem csak hozzájárul a környezetvédelemhez, de segíti a biológiai sokféleség megőrzését is, ez pedig a jövőben fontosabb lesz, mint gondolnánk
A fenntartható divat nem csak hozzájárul a környezetvédelemhez, de segíti a biológiai sokféleség megőrzését is, ez pedig a jövőben fontosabb lesz, mint gondolnánk

Életmód
 „Az embereket kell félteni, nekik nem lesz életterük, ha elpusztítják a környezetet” - Interjú Juhász Szép Annával
„Az embereket kell félteni, nekik nem lesz életterük, ha elpusztítják a környezetet” - Interjú Juhász Szép Annával

 A biodizájnereké a jövő - az igazán környezettudatos divattervező már nem csak rajzol, hanem termeszt is
A biodizájnereké a jövő - az igazán környezettudatos divattervező már nem csak rajzol, hanem termeszt is

Rózsaszínre festette az esküvői ruháját, majd vendégként ment benne esküvőre: a végeredmény lélegzetelállító

 A fenntarthatóbb divatipar a közös ügyünk - az Európai Unió textilipari szabályozásai
A fenntarthatóbb divatipar a közös ügyünk - az Európai Unió textilipari szabályozásai

 Be kell látni, hogy egy véges erőforrásokkal rendelkező bolygón nincs végtelen növekedési lehetőség - Szakértőkkel a klímaváltozásról
Be kell látni, hogy egy véges erőforrásokkal rendelkező bolygón nincs végtelen növekedési lehetőség - Szakértőkkel a klímaváltozásról

 Tévedsz, ha a second hand üzletekben látod a fenntarthatóság jövőjét - Mutatjuk, hogy csináld!
Tévedsz, ha a second hand üzletekben látod a fenntarthatóság jövőjét - Mutatjuk, hogy csináld!
